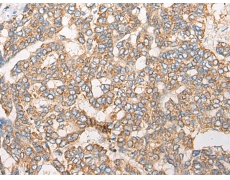
一抗

中文名稱: 兔抗ARF3多克隆抗體
|
Background: |
ADP-ribosylation factor 3 (ARF3) is a member of the human ARF gene family. These genes encode small guanine nucleotide-binding proteins that stimulate the ADP-ribosyltransferase activity of cholera toxin and play a role in vesicular trafficking and as activators of phospholipase D. The gene products include 6 ARF proteins and 11 ARF-like proteins and constitute 1 family of the RAS superfamily. The ARF proteins are categorized as class I (ARF1, ARF2,and ARF3), class II (ARF4 and ARF5) and class III (ARF6) and members of each class share a common gene organization. The ARF3 gene contains five exons and four introns. |
|
Applications: |
ELISA, IHC |
|
Name of antibody: |
ARF3 |
|
Immunogen: |
Synthetic peptide of human ARF3 |
|
Full name: |
ADP ribosylation factor 3 |
|
SwissProt: |
P61204 |
|
ELISA Recommended dilution: |
5000-10000 |
|
IHC positive control: |
Human liver cancer; Human esophagus cancer |
|
IHC Recommend dilution: |
25-100 |


 購物車
購物車 幫助
幫助
 021-54845833/15800441009
021-54845833/15800441009